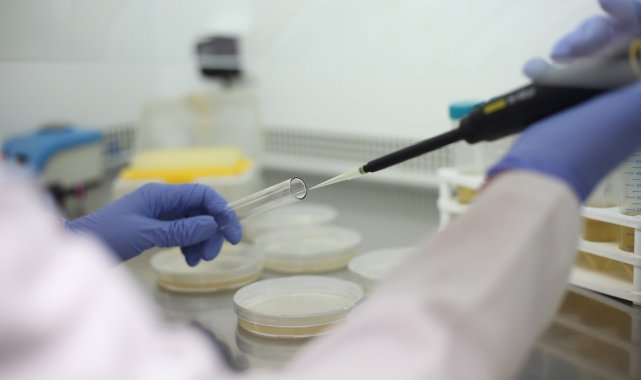
PAÜ'nün askeri projesine TÜBİTAK'tan destek

PAÜ'nün askeri projesine TÜBİTAK'tan destek
DENİZLİ (İHA) – Pamukkale Üniversitesi (PAÜ) Öğretim Üyesi Prof. Dr. Ahmet Koluman'ın yürütücüsü olduğu proje TÜBİTAK tarafından destek almaya hak kazandı. Savunma sanayinde askerin herhangi bir kaynaktan temiz içme suyunu pratik bir şekilde elde edebilmesini sağlayacak olan bu sistem, farklı birçok özelliği ile ön plana çıkıyor.
Yayınlanma :
31.12.2021 09:29
Güncelleme :
31.12.2021 09:36

PAÜ Teknoloji Fakültesi Öğretim Üyesi Prof. Dr. Ahmet Koluman'ın yürütücülüğünde gerçekleştirilen, Askeri Personel İçin Nanolifli ve Örme Kumaş Filtreli Taşınabilir Su Filtrasyon Cihaz Tasarımı Projesi, TÜBİTAK ARDEB 1001 Bilimsel ve Teknolojik Araştırma Projelerini Destekleme Programı kapsamında, destek almaya hak kazandı. Projede, yine PAÜ Denizli Teknik Bilimler MYO Öğretim Üyesi Doç. Dr. Çiğdem Akduman ve Biyomedikal Mühendisi Mahmet Sari Njjar görev alıyor. Proje Eskişehir Teknik Üniversitesi Endüstriyel Tasarım Bölümünden Dr. Öğr. Üyesi Emre Tüfekçioğlu, Barış Derviş, OSTİM Teknik Üniversitesi'nden Yüksek Mühendis Mehmet Can Türk ve Nanofiber Tekstil Teknolojileri ve Makineleri San ve Tic. Ltd. Şti. Sahibi Yüksek Mühendis Çetin Aka ile Ozan Tekstil Ar-Ge Birimi'nden Mustafa Çörekçioğlu ile Sultan Aras beraberliğinde yürütülecek. Projeye, Milli Savunma Bakanlığı KBRN Daire Başkanı Dr. Burçak Çabuk'un tam desteği bulunuyor.
Özellikle askeri personelin kullanımına uygun olarak tasarlanacak su filtrasyon cihazı ile manevra halindeki askeri personel, bulduğu her hangi bir ortamdaki suyu kolaylıkla içme suyuna dönüştürebilecek. Askeri Personel İçin Nanolifli ve Örme Kumaş Filtreli Taşınabilir Su Filtrasyon Cihaz Tasarımı Projesi, Proje Yürütücüsü Prof. Dr. Ahmet Koluman tasarlayacakları cihaz ile ilgili olarak şunları söyledi: "Bu proje, özellikle suya erişimi olmayan manevra halindeki askerlerin suya erişimini sağlayacak bir filtrasyon sistemi projesidir. Bu sistem, sadece savunma sanayinde değil ekstrem sporlar yapan sporcular tarafından da kullanılabilecek bir sistem. Sistemin en büyük özelliği tek parmakla kullanılabilir olması ve sessiz çalışmasıdır. Filtresinin özellikle deniz bölgesine özgü tekstil geleneklerini devam ettirecek şekilde kullanılması hedeflenmektedir. Literatür taramaları ve patent aramalarında tarafımızdan önerilen sistem şeklinde herhangi bir dokümantasyona biz denk gelmedik. Bu yönüyle de son derece özgün bir çalışmadır. Sistem, sadece tekstil değil aynı zamanda normal iplerle de güçlendirilmiş bir yapıyı içermektedir. Operasyonda bulunan askerlerin yanında su taşımak yerine sadece bu akıllı sistemi taşıması sayesinde bulduğu herhangi bir su kaynağından güvenilir, mikroorganizma içermeyen ve ağır metallerden arındırılmış bir içme suyu elde edebilmelerini hedefliyoruz. Bilindiği üzere askeri çantalardaki yükün çok daha hafif olması askerin manevra kabiliyeti ve savunma sanayi açısından bir o kadar önemlidir. Bu faydaların yanında içilebilir su kaynaklarının azaldığı günümüzde bireylerin herhangi bir kaynaktan içilebilir su elde etmesi çok daha pratik hale gelecektir"
Yorum Yazma Kuralları
Lütfen yorum yaparken veya bir yorumu yanıtlarken aşağıda yer alan yorum yazma kurallarına dikkat ediniz.
Türkiye Cumhuriyeti yasalarına aykırı, suç veya suçluyu övme amaçlı yorumlar yapmayınız.
Küfür, argo, hakaret içerikli, nefret uyandıracak veya nefreti körükleyecek yorumlar yapmayınız.
Irkçı, cinsiyetçi, kişilik haklarını zedeleyen, taciz amaçlı veya saldırgan ifadeler kullanmayınız.
Türkçe imla kurallarına ve noktalama işaretlerine uygun cümleler kurmaya özen gösteriniz.
Yorumunuzu tamamı büyük harflerden oluşacak şekilde yazmayınız.
Gizli veya açık biçimde reklam, tanıtım amaçlı yorumlar yapmayınız.
Kendinizin veya bir başkasının kişisel bilgilerini paylaşmayınız.
Yorumlarınızın hukuki sorumluluğunu üstlendiğinizi, talep edilmesi halinde bilgilerinizin yetkili makamlarla paylaşılacağını unutmayınız.












Yorumlar
Kalan Karakter: